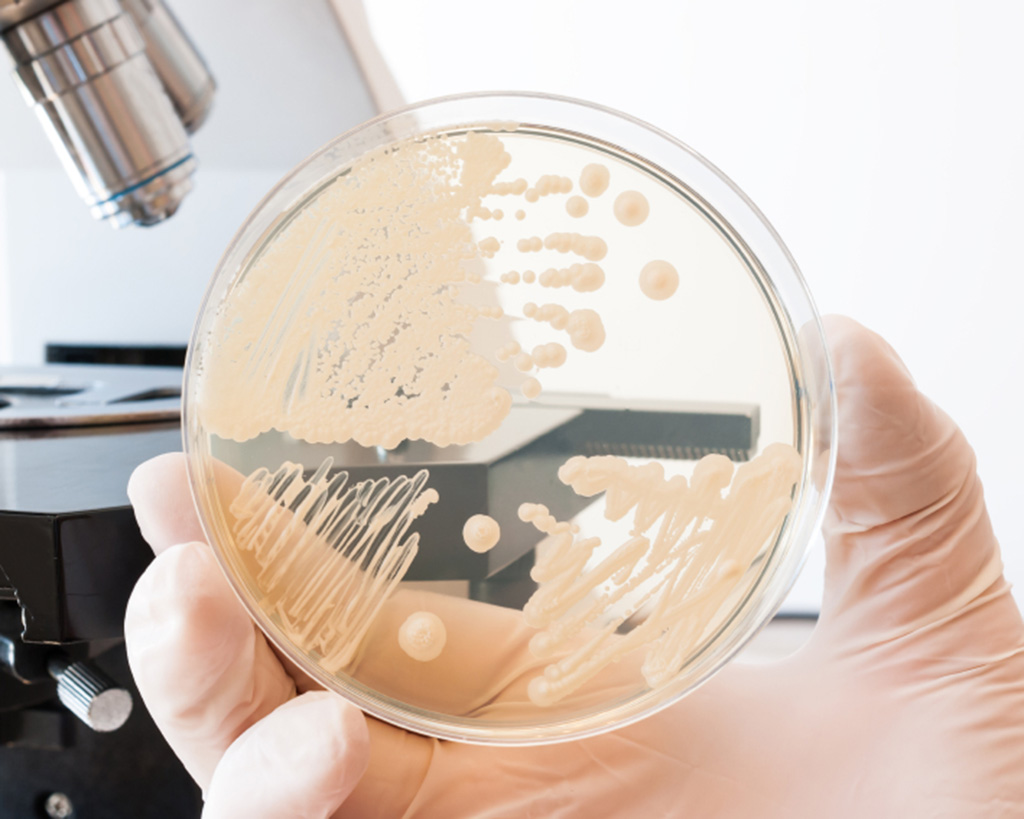
Analisi microbiologiche

Analisi alimentari

Merceologiche e nutrizionali
Ai fini del controllo dell’etichettatura nutrizionale (Regolamento Ue n. 1169/2011) è necessario effettuare una serie di analisi sia sugli alimenti che sulle materie prime, secondo metodi riconosciuti e normati. AGROLAB Italia S.r.l. verifica la conformità merceologica dell’alimento tenendo in considerazione la normativa vigente, la corrispondenza ai capitolati e la commerciabilità del prodotto.

Residui nei prodotti alimentari
La ricerca dei residui indesiderati negli alimenti sta alla base della qualità dell’alimento. Per fornire al consumatore un prodotto salubre e conforme agli standard previsti dalle normative vigenti è necessario effettuare numerosi controlli con strumentazione idonea che garantisca un’adeguata sensibilità e la corretta identificazione dei contaminanti individuati.
Analisi microbiologiche
Il controllo microbiologico di un prodotto alimentare rappresenta uno step primario per la valutazione della qualità dell’alimento e per la verifica di eventuali contaminazioni e del rischio per il consumatore. AGROLAB Italia S.r.l. esegue la determinazione di patogeni e non per garantire la sicurezza del prodotto alimentare o la corretta attuazione del sistema di autocontrollo HACCP.

Radioattività su prodotti alimentari
AGROLAB può vantare anni di esperienza e attrezzature all'avanguardia nelle analisi di isotopi radioattivi su prodotti alimentari. Le nostre competenze partono da regolari controlli su acque minerali per analisi su radioisotopi naturali o artificiali, passando per le misurazioni effettuate a carico di paesi sottostanti a direttive per l'importazione, fino ad arrivare ad analisi di incidenti come quello accaduto a Fukushima.

PFAS negli alimenti
Determiniamo i PFAS negli alimenti e nei mangimi utilizzando tecniche LC-MS/MS ad alta sensibilità e analizziamo tutti i composti rilevanti in conformità ai requisiti UE vigenti. AGROLAB GROUP fornisce risultati precisi e accreditati per diverse matrici e supporta i clienti nei programmi di monitoraggio e nel rispetto dei limiti stabiliti dal regolamento (UE) 2023/915 e dalla raccomandazione (UE) 2022/1431. Le nostre analisi rappresentano una base affidabile per decisioni solide e conformi alla normativa.
Contatti
CARRIERA
Contatti